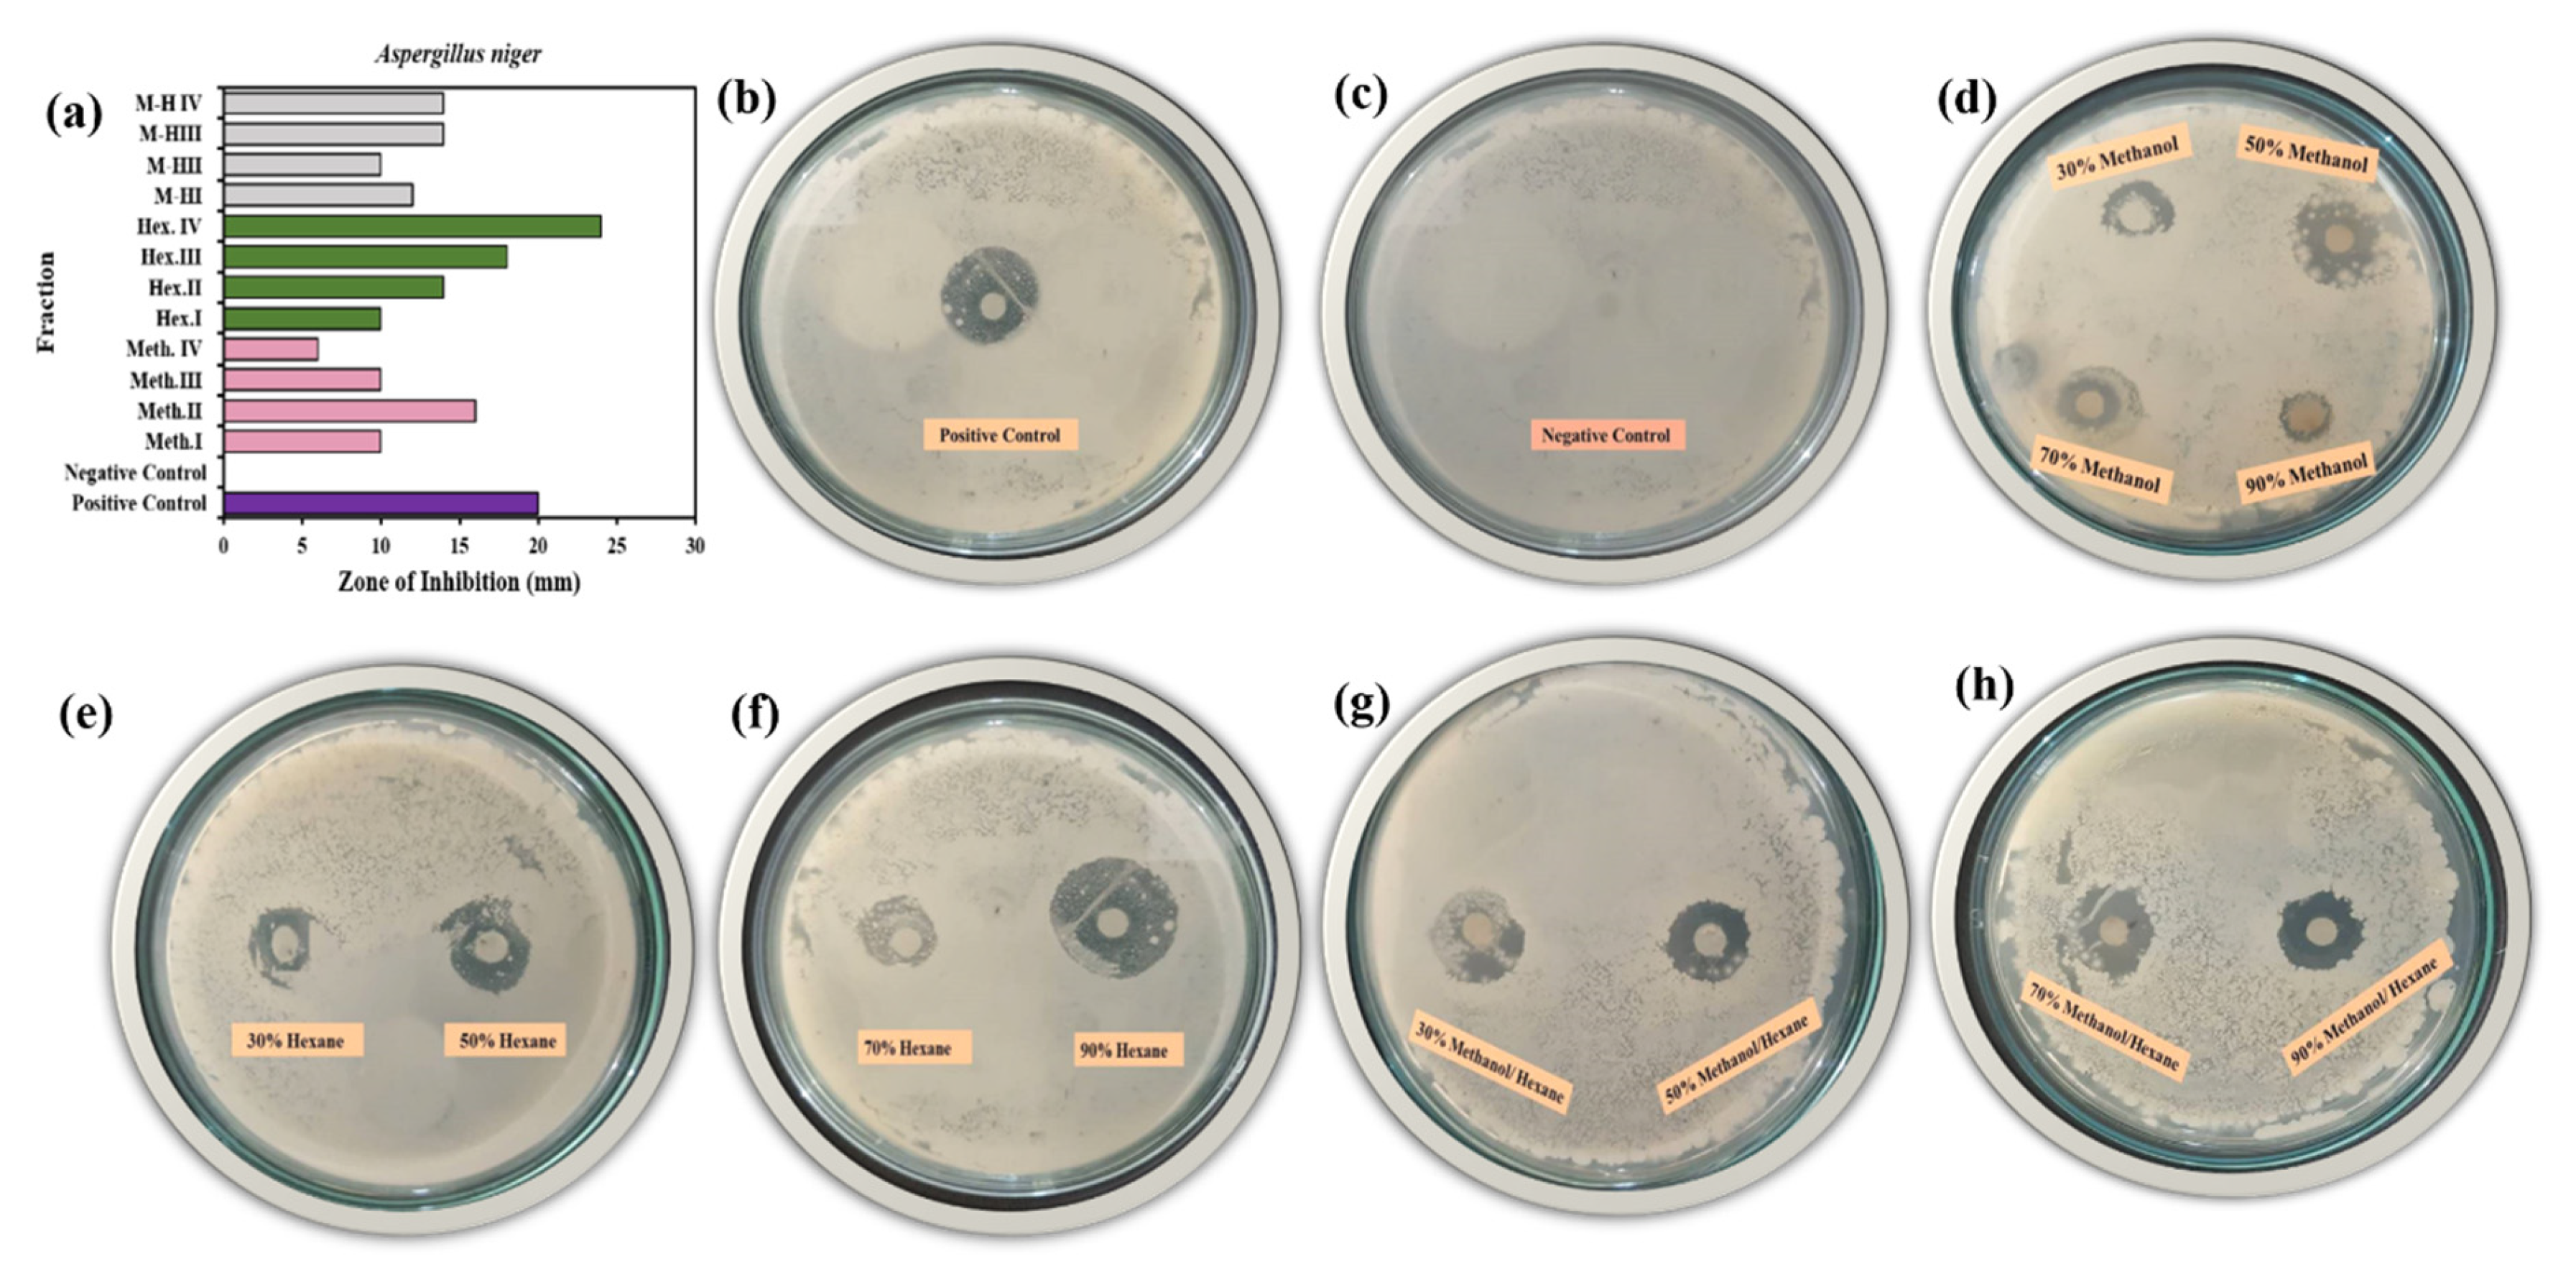
Molecules 25 03478 g009 Molecules 25 03478 g009
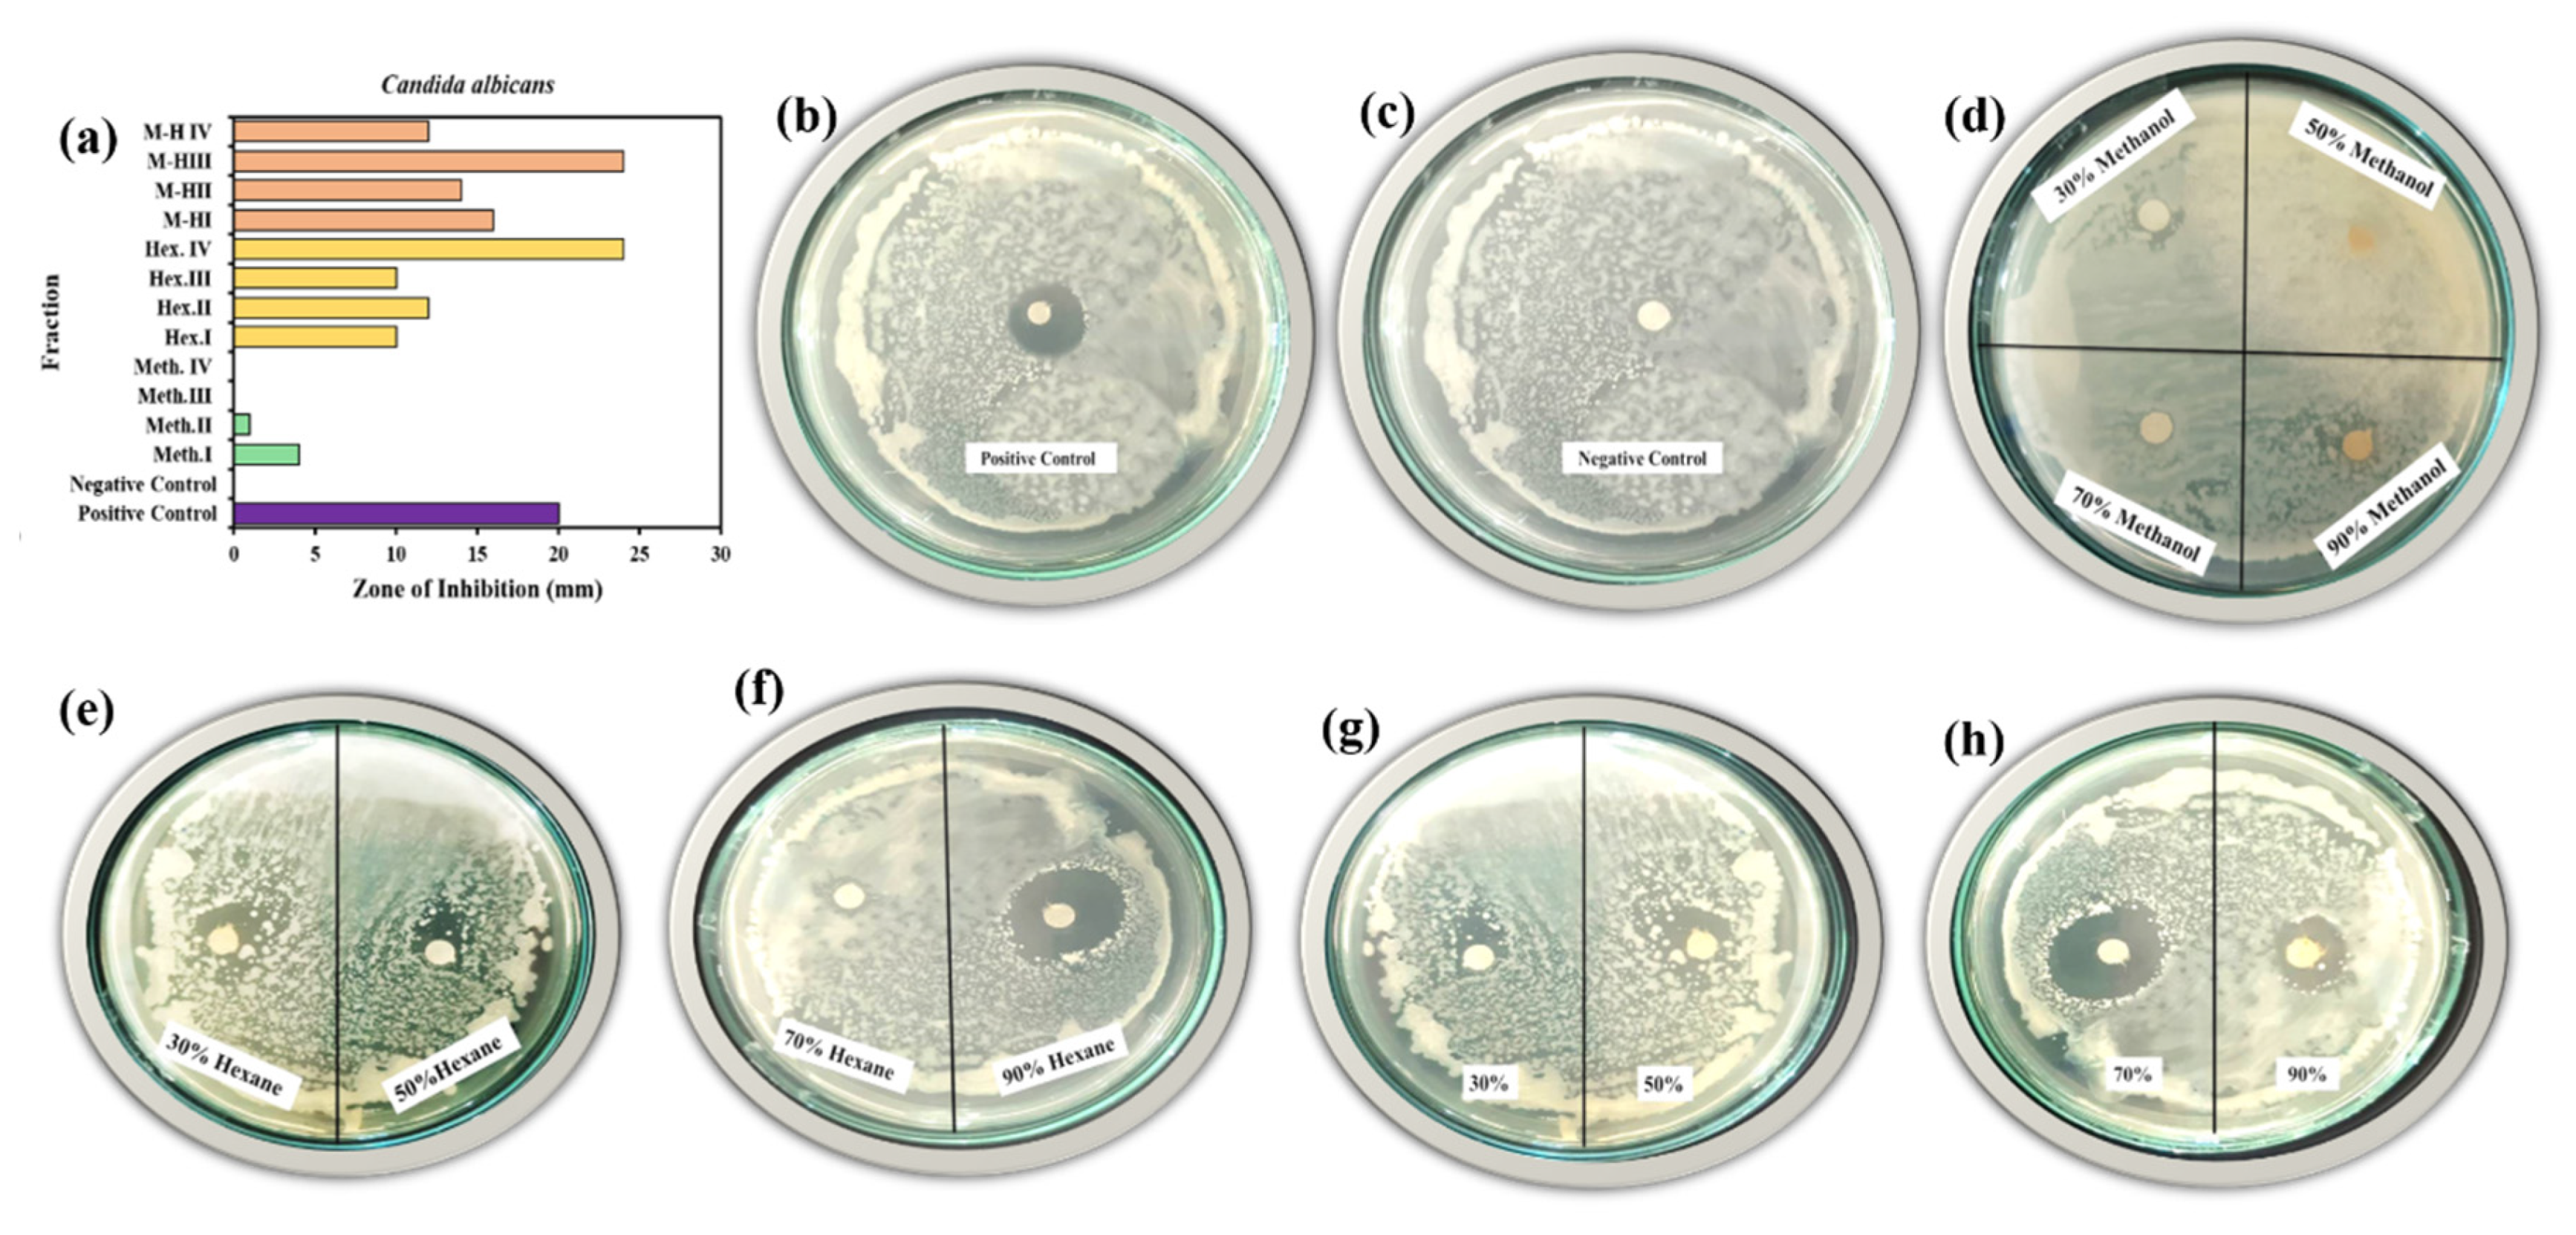
Molecules 25 03478 g010 Molecules 25 03478 g010

Fractionation of Biomolecules in Withania coagulans Extract for Bioreductive Nanoparticle Synthesis, Antifungal and Biofilm Activity
Abstract
1. Introduction
2. Results
2.1. Green Synthesis of Co3O4 NPs
2.1.1. Characterization of Green Synthesized Co3O4 NPs
2.1.2. XRD Analysis of Co3O4 NPs
2.2. Biofilm Activity of Prepared W. coagulans Fractions
2.3. Antibiotic Selectivity
2.3.1. Biofilm Inhibition Potential of W. coagulans Fraction against P. aeruginosa
2.3.2. Biofilm Inhibition Potential of W. coagulans Fractions against S. aureus
2.4. Antifungal Activity of Prepared W. coagulans Fractions
2.4.1. Antifungal Activity of Prepared W. coagulans against A. Niger
2.4.2. Antifungal Activity of Prepared W. coagulans against C. albicans
3. Materials and Methods
3.1. Plant Material
3.2. Preparation of Plant Extract
3.3. Synthesis of Cobalt Oxide Nanoparticles
3.4. UV-Vis Spectroscopy
3.5. Morphology Analysis of via Compound Microscope
3.6. Biofilm Assay of W. coagulans Fraction
3.7. Antifungal Activity of W. coagulans Fraction
4. Conclusions
Supplementary Materials
Author Contributions
Funding
Acknowledgments
Conflicts of Interest
References
- Blair, J.M.A.; A Webber, M.; Baylay, A.J.; Ogbolu, D.O.; Piddock, L.J.V. Molecular mechanisms of antibiotic resistance. Nat. Rev. Genet. 2014, 13, 42–51. [Google Scholar] [CrossRef] [PubMed]
- De Kievit, T. Biofilms. Compr. Biotechnol. 2011, 1, 529–540. [Google Scholar] [CrossRef]
- Hall-Stoodley, L.; Costerton, J.W.; Stoodley, P. Bacterial biofilms: From the Natural environment to infectious diseases. Nat. Rev. Genet. 2004, 2, 95–108. [Google Scholar] [CrossRef] [PubMed]
- Abu Bakar, M.; McKimm, J.; Haque, S.Z.; Majumder, A.A.; Haque, M. Chronic tonsillitis and biofilms: A brief overview of treatment modalities. J. Inflamm. Res. 2018, 11, 329–337. [Google Scholar] [CrossRef]
- Orazi, G.; Ruoff, K.L.; O’Toole, G.A.; Wright, G.; Gilmore, M. Pseudomonas aeruginosa Increases the Sensitivity of Biofilm-Grown Staphylococcus aureus to Membrane-Targeting Antiseptics and Antibiotics. mBio 2019, 10, e01501-19. [Google Scholar] [CrossRef] [PubMed]
- Dadar, M.; Tiwari, R.; Karthik, K.; Chakraborty, S.; Shahali, Y.; Dhama, K. Candida albicans—Biology, molecular characterization, pathogenicity, and advances in diagnosis and control—An update. Microb. Pathog. 2018, 117, 128–138. [Google Scholar] [CrossRef] [PubMed]
- Cannon, R.D.; Chaffin, W. Oral Colonization By Candida Albicans. Crit. Rev. Oral Boil. Med. 1999, 10, 359–383. [Google Scholar] [CrossRef]
- Nyirjesy, P. Management of Persistent Vaginitis. Obstet. Gynecol. 2014, 124, 1135–1146. [Google Scholar] [CrossRef]
- Gavaldà, J.; Meije, Y.; Fortun, J.; Roilides, E.; Saliba, F.; Lortholary, O.; Muñoz, P.; Grossi, P.; Cuenca-Estrella, M. Invasive fungal infections in solid organ transplant recipients. Clin. Microbiol. Infect. 2014, 20, 27–48. [Google Scholar] [CrossRef]
- Kosmidis, C.; Denning, D. The clinical spectrum of pulmonary aspergillosis. Thorax 2014, 70, 270–277. [Google Scholar] [CrossRef]
- Slobodníková, L.; Fialová, S.; Rendeková, K.; Kováč, J.; Mučaji, P. Antibiofilm Activity of Plant Polyphenols. Molecules 2016, 21, 1717. [Google Scholar] [CrossRef]
- Clain, E.; Haddad, J.G.; Koishi, A.C.; Sinigaglia, L.; Rachidi, W.; Despres, P.; Dos Santos, C.N.D.; Guiraud, P.; Jouvenet, N.; El Kalamouni, C.; et al. The Polyphenol-Rich Extract from Psiloxylon mauritianum, an Endemic Medicinal Plant from Reunion Island, Inhibits the Early Stages of Dengue and Zika Virus Infection. Int. J. Mol. Sci. 2019, 20, 1860. [Google Scholar] [CrossRef] [PubMed]
- Ren, Z.; Chen, L.; Li, J.; Li, Y. Inhibition ofStreptococcus mutanspolysaccharide synthesis by molecules targeting glycosyltransferase activity. J. Oral Microbiol. 2016, 8, 623. [Google Scholar] [CrossRef] [PubMed]
- Ichikawa, H. Withanolides potentiate apoptosis, inhibit invasion, and abolish osteoclastogenesis through suppression of nuclear factor-B (NF-B) activation and NF-B-regulated gene expression. Mol. Cancer Ther. 2006, 5, 1434–1445. [Google Scholar] [CrossRef] [PubMed]
- Salwaan, C.; Singh, A.; Mittal, A.; Singh, P. Investigation of the Pharmacognostical, Phytochemical and Antioxidant Studies of Plant Withania coagulans Dunal. J. Pharmacogn. Phytochem. 2012, 1, 32–39. [Google Scholar]
- Gupta, P.C. Withania coagulans Dunal—An overview. Int. J. Pharm. Sci. Rev. Res. 2012, 11, 448–451. [Google Scholar]
- Prasad, S.; Singh, P.; Wahi, A.; Hemalatha, S. Pharmacognostical Standardization of Withania coagulans Dunal. Pharmacogn. J. 2010, 2, 386–394. [Google Scholar] [CrossRef]
- Ismail, H.; Rasheed, A.; Haq, I.-U.; Jafri, L.; Ullah, N.; Dilshad, E.; Sajid, M.; Mirza, B. Five Indigenous Plants of Pakistan with Antinociceptive, Anti-Inflammatory, Antidepressant, and Anticoagulant Properties in Sprague Dawley Rats. Evid.-Based Complement Altern. Med. 2017, 2017, 1–10. [Google Scholar] [CrossRef]
- Ahmad, R.; Fatima, A.; Srivastava, A.; Khan, M.A. Evaluation of apoptotic activity of Withania coagulans methanolic extract against human breast cancer and Vero cell lines. J. Ayurveda Integr. Med. 2017, 8, 177–183. [Google Scholar] [CrossRef]
- Maurya, R.; Akanksha; Jayendra; Singh, A.B.; Srivastava, A.K. Coagulanolide, a withanolide from Withania coagulans fruits and antihyperglycemic activity. Bioorganic Med. Chem. Lett. 2008, 18, 6534–6537. [Google Scholar] [CrossRef]
- Gupta, V.; Keshari, B.B. Withania Coagulans Dunal. (Paneer Doda): A Review. Int. J. Ayurvedic Herb. Med. 2013, 3, 1330–1336. [Google Scholar]
- Khodaei, M.; Jafari, M.; Noori, M. Remedial Use of Withanolides from Withania Coagolans (Stocks) Dunal. Adv. Life Sci. 2012, 2, 6–19. [Google Scholar] [CrossRef]
- Qasim, S.; Zafar, A.; Saif, M.S.; Ali, Z.; Nazar, M.; Waqas, M.; Haq, A.U.; Tariq, T.; Hassan, S.G.; Iqbal, F.; et al. Green synthesis of iron oxide nanorods using Withania coagulans extract improved photocatalytic degradation and antimicrobial activity. J. Photochem. Photobiol. B Biol. 2020, 204, 111784. [Google Scholar] [CrossRef] [PubMed]
- Tripathi, D.; Modi, A.; Narayan, G.; Rai, S.P. Green and cost effective synthesis of silver nanoparticles from endangered medicinal plant Withania coagulans and their potential biomedical properties. Mater. Sci. Eng. C 2019, 100, 152–164. [Google Scholar] [CrossRef] [PubMed]
- Maurya, R.; And, A. Jayendra Chemistry and pharmacology of Withania coagulans: An Ayurvedic remedy. J. Pharm. Pharmacol. 2010, 62, 153–160. [Google Scholar] [CrossRef]
- Yousaf, M.; Ahmad, M.; Bhatti, I.A.; Nasir, A.; Hasan, M.; Jian, X.; Kalantar-Zadeh, K.; Mahmood, N. In Vivo and In Vitro Monitoring of Amyloid Aggregation via BSA@FGQDs Multimodal Probe. ACS Sens. 2018, 4, 200–210. [Google Scholar] [CrossRef]
- Hasan, M.; Zafar, A.; Yousaf, M.; Gulzar, H.; Mehmood, K.; Hassan, S.G.; Saeed, A.; Yousaf, A.; Mazher, A.; Rongji, D.; et al. Synthesis of Loureirin B-Loaded Nanoliposomes for Pharmacokinetics in Rat Plasma. ACS Omega 2019, 4, 6914–6922. [Google Scholar] [CrossRef]
- Kim, S.; Yu, J.S.; Lee, J.Y.; Choi, S.U.; Lee, J.; Kim, K.H. Cytotoxic Withanolides from the Roots of Indian Ginseng (Withania somnifera). J. Nat. Prod. 2019, 82, 765–773. [Google Scholar] [CrossRef]
- Kaur, A.; Singh, B.; Ohri, P.; Wang, J.; Wadhwa, R.; Kaul, S.C.; Pati, P.K.; Kaur, A. Organic cultivation of Ashwagandha with improved biomass and high content of active Withanolides: Use of Vermicompost. PLoS ONE 2018, 13, e0194314. [Google Scholar] [CrossRef]
- Vaishnavi, K.; Saxena, N.; Shah, N.; Singh, R.; Manjunath, K.; Uthayakumar, M.; Kanaujia, S.P.; Kaul, S.C.; Sekar, K.; Wadhwa, R. Differential Activities of the Two Closely Related Withanolides, Withaferin A and Withanone: Bioinformatics and Experimental Evidences. PLoS ONE 2012, 7, e44419. [Google Scholar] [CrossRef]
- Rai, M.K.; Jogee, P.S.; Agarkar, G.; Dos Santos, C.A. Anticancer activities of Withania somnifera: Current research, formulations, and future perspectives. Pharm. Biol. 2015, 54, 189–197. [Google Scholar] [CrossRef]
- Yousaf, A.; Zafar, A.; Ali, M.; Bukhary, S.M.; Manzoor, Y.; Tariq, T.; Saeed, A.; Akram, M.; Bukhari, F.; Abdullah, M.; et al. Intrinsic Bio-Enhancer Entities of Fagonia cretica for Synthesis of Silver Nanoparticles Involves Anti-Urease, Anti-Oxidant and Anti-Tyosinase Activity. Adv. Biosci. Biotechnol. 2019, 10, 455–468. [Google Scholar] [CrossRef]
- Zulfiqar, H.; Zafar, A.; Rasheed, M.N.; Ali, Z.; Mehmood, K.; Mazher, A.; Hasan, M.; Mahmood, N.; Ayesha, Z.; Rasheed, N. Synthesis of silver nanoparticles using Fagonia cretica and their antimicrobial activities. Nanoscale Adv. 2019, 1, 1707–1713. [Google Scholar] [CrossRef]
- Hasan, M.; Teng, Z.; Iqbal, J.; Awan, U.; Meng, S.; Dai, R.; Qing, H.; Deng, Y. Assessment of Bioreducing and Stabilizing Potential of Dragon’s Blood (Dracaena Cochinchinensis, Lour. S. C. Chen) Resin Extract in Synthesis of Silver Nanoparticles. Nanosci. Nanotechnol. Lett. 2013, 5, 780–784. [Google Scholar] [CrossRef]
- Hasan, M.; Iqbal, J.; Awan, U.; Saeed, Y.; RanRan, Y.; Liang, Y.; Dai, R.; Deng, Y. Mechanistic Study of Silver Nanoparticle’s Synthesis by Dragon’s Blood Resin Ethanol Extract and Antiradiation Activity. J. Nanosci. Nanotechnol. 2015, 15, 1320–1326. [Google Scholar] [CrossRef] [PubMed]
- Hasan, M.; Ullah, I.; Zulfiqar, H.; Naeem, K.; Iqbal, A.; Gul, H.; Ashfaq, M.; Mahmood, N. Biological entities as chemical reactors for synthesis of nanomaterials: Progress, challenges and future perspective. Mater. Today Chem. 2018, 8, 13–28. [Google Scholar] [CrossRef]
- Akbar, S.; Haleem, K.S.; Tauseef, I.; Rehman, W.; Ali, N.; Hasan, M. Raphanus sativus Mediated Synthesis, Characterization and Biological Evaluation of Zinc Oxide Nanoparticles. Nanosci. Nanotechnol. Lett. 2017, 9, 2005–2012. [Google Scholar] [CrossRef]
- Mahmood, S.; Fatima, T.; Zulfaqar, H.; Saher, R.; Rafiq, M.; Rehman, A.; Dai, R.; Ashfaq, M.; Hasan, M. Meta-analysis of dragon’s blood resin extract as radio-protective agent. J. Coast. Life Med. 2017, 409–416. [Google Scholar] [CrossRef]
- Munawar, T.; Yasmeen, S.; Hasan, M.; Mahmood, K.; Hussain, A.; Ali, A.; Arshad, M.; Iqbal, F. Novel tri-phase heterostructured ZnO–Yb2O3–Pr2O3 nanocomposite; structural, optical, photocatalytic and antibacterial studies. Ceram. Int. 2020, 46, 11101–11114. [Google Scholar] [CrossRef]
- Munawar, T.; Yasmeen, S.; Mukhtar, F.; Nadeem, M.S.; Mahmood, K.; Saif, M.S.; Hasan, M.; Ali, A.; Hussain, F.; Iqbal, F. Zn0.9Ce0.05M0.05O (M = Er, Y, V) nanocrystals: Structural and energy bandgap engineering of ZnO for enhancing photocatalytic and antibacterial activity. Ceram. Int. 2020, 46, 14369–14383. [Google Scholar] [CrossRef]
- Fathalipour, S.; Pourbeyram, S.; Sharafian, A.; Tanomand, A.; Azam, P. Biomolecule-assisted synthesis of Ag/reduced graphene oxide nanocomposite with excellent electrocatalytic and antibacterial performance. Mater. Sci. Eng. C 2017, 75, 742–751. [Google Scholar] [CrossRef] [PubMed]
- Somu, P.; Paul, S.; S, P. A biomolecule-assisted one-pot synthesis of zinc oxide nanoparticles and its bioconjugate with curcumin for potential multifaceted therapeutic applications. New J. Chem. 2019, 43, 11934–11948. [Google Scholar] [CrossRef]
- Hasan, M.; Iqbal, J.; Awan, U.; Xin, N.; Dang, H.; Waryani, B.; Saeed, Y.; Ullah, K.; Rongji, D.; Deng, Y. LX loaded nanoliposomes synthesis, characterization and cellular uptake studies in H2O2 stressed SH-SY5Y cells. J. Nanosci. Nanotechnol. 2014, 14, 4066–4071. [Google Scholar] [CrossRef] [PubMed]
- Ran, Y.; Wang, R.; Hasan, M.; Jia, Q.; Tang, B.; Shan, S.; Deng, Y.; Qing, H. Radioprotective effects of dragon’s blood and its extracts on radiation-induced myelosuppressive mice. J. Ethnopharmacol. 2014, 154, 624–634. [Google Scholar] [CrossRef] [PubMed]
- Ran, Y.; Wang, R.; Gao, Q.; Jia, Q.; Hasan, M.; Awan, M.U.F.; Tang, B.; Zhou, R.; Dong, Y.; Wang, X.; et al. Dragon’s blood and its extracts attenuate radiation-induced oxidative stress in mice. J. Radiat. Res. 2014, 55, 699–706. [Google Scholar] [CrossRef]
- Ran, Y.; Wang, R.; Lin, F.; Hasan, M.; Jia, Q.; Tang, B.; Xia, Y.; Shan, S.; Wang, X.; Li, Q.; et al. Radioprotective effects of Dragon’s blood and its extract against gamma irradiation in mouse bone marrow cells. Phys. Med. 2014, 30, 427–431. [Google Scholar] [CrossRef] [PubMed]
- Petrachi, T.; Resca, E.; Piccinno, M.S.; Biagi, F.; Strusi, V.; Dominici, M.; Veronesi, E. An Alternative Approach to Investigate Biofilm in Medical Devices: A Feasibility Study. Int. J. Environ. Res. Public Health 2017, 14, 1587. [Google Scholar] [CrossRef]
- Good, M.; Wend, C.; Bond, L.; McLean, J.S.; Panetta, P.; Ahmed, S.; Crawford, S.; Daly, D. An estimate of biofilm properties using an acoustic microscope. IEEE Trans. Ultrason. Ferroelectr. Freq. Control 2006, 53, 1637–1648. [Google Scholar] [CrossRef]
- Biswas, B.; Rogers, K.; McLaughlin, F.; Daniels, D.; Yadav, A. Antimicrobial Activities of Leaf Extracts of Guava (Psidium guajavaL.) on Two Gram-Negative and Gram-Positive Bacteria. Int. J. Microbiol. 2013, 2013, 1–7. [Google Scholar] [CrossRef]
- Türeli, N.G.; Torge, A.; Juntke, J.; Schwarz, B.C.; Schneider-Daum, N.; Türeli, A.E.; Lehr, C.-M.; Schneider, M. Ciprofloxacin-loaded PLGA nanoparticles against cystic fibrosis P. aeruginosa lung infections. Eur. J. Pharm. Biopharm. 2017, 117, 363–371. [Google Scholar] [CrossRef]
- Manandhar, S.; Luitel, S.; Dahal, R.K. In Vitro Antimicrobial Activity of Some Medicinal Plants against Human Pathogenic Bacteria. J. Trop. Med. 2019, 2019, 1895340-5. [Google Scholar] [CrossRef]
- Samadi, F.M.; Suhail, S.; Sonam, M.; Sharma, N.; Singh, S.; Gupta, S.; Dobhal, A.; Pradhan, H. Antifungal efficacy of herbs. J. Oral Biol. Craniofacial Res. 2018, 9, 28–32. [Google Scholar] [CrossRef] [PubMed]
- Hamill, R.J. Amphotericin B Formulations: A Comparative Review of Efficacy and Toxicity. Drugs 2013, 73, 919–934. [Google Scholar] [CrossRef] [PubMed]
Sample Availability: Samples of the compounds are available from the authors. |

| Samples | a(Å) | b(Å) | c(Å) | d-Spacing | Volume (Å3) | Crystallite Size (nm) | Dislocation Density δ (nm)−2 × 10−4 |
|---|---|---|---|---|---|---|---|
| A | 8.04702 | - | - | 1.8365 | 521.0805 | 50 | 4.000 |
| B | 8.07016 | - | - | 1.9657 | 525.5884 | 59 | 2.870 |
| C | 8.06895 | - | - | 1.8362 | 525.3527 | 49 | 4.160 |
© 2020 by the authors. Licensee MDPI, Basel, Switzerland. This article is an open access article distributed under the terms and conditions of the Creative Commons Attribution (CC BY) license (http://creativecommons.org/licenses/by/4.0/).
Share and Cite
Hasan, M.; Zafar, A.; Shahzadi, I.; Luo, F.; Hassan, S.G.; Tariq, T.; Zehra, S.; Munawar, T.; Iqbal, F.; Shu, X. Fractionation of Biomolecules in Withania coagulans Extract for Bioreductive Nanoparticle Synthesis, Antifungal and Biofilm Activity. Molecules 2020, 25, 3478. https://doi.org/10.3390/molecules25153478
Hasan M, Zafar A, Shahzadi I, Luo F, Hassan SG, Tariq T, Zehra S, Munawar T, Iqbal F, Shu X. Fractionation of Biomolecules in Withania coagulans Extract for Bioreductive Nanoparticle Synthesis, Antifungal and Biofilm Activity. Molecules. 2020; 25(15):3478. https://doi.org/10.3390/molecules25153478
Chicago/Turabian StyleHasan, Murtaza, Ayesha Zafar, Irum Shahzadi, Fan Luo, Shahbaz Gul Hassan, Tuba Tariq, Sadaf Zehra, Tauseef Munawar, Faisal Iqbal, and Xugang Shu. 2020. "Fractionation of Biomolecules in Withania coagulans Extract for Bioreductive Nanoparticle Synthesis, Antifungal and Biofilm Activity" Molecules 25, no. 15: 3478. https://doi.org/10.3390/molecules25153478
APA StyleHasan, M., Zafar, A., Shahzadi, I., Luo, F., Hassan, S. G., Tariq, T., Zehra, S., Munawar, T., Iqbal, F., & Shu, X. (2020). Fractionation of Biomolecules in Withania coagulans Extract for Bioreductive Nanoparticle Synthesis, Antifungal and Biofilm Activity. Molecules, 25(15), 3478. https://doi.org/10.3390/molecules25153478

